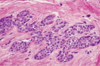
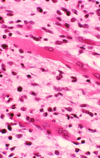

Week 1 Flashcards
(80 cards)
What are the general epidemiology, etiology, and symptoms for urogenital dysfunction?
- Epidemiology: 10-60% woman, elderly
- Etiology: vaginal delivery, aging, estrogen deficiency, neurological/psychological disease
- Symptoms: frequency, nocturia, dysuria, incomplete emptying, incontinence, urgency, recurrent infections, dyspareunia, prolapse
For stress incontinence:
- Provide pathophys and etiology
- Stress incontinence
- Pathophysiology: increases in abdominal pressure (cough, laugh, lifting) → loss of urine
- Etiology: pelvic floor damage OR weak sphincters
For urge incontinence:
- Provide pathophys and presentation
- Urge incontinence (OAB)
- Pathophysiology: involuntary bladder contractions → loss of urine (complete emptying)
- Presentation: Urinating 15-20 times a day
For mixed incontinence:
- Provide pathophys
- Mixed incontinence
- Pathophysiology: combination of stress and urge incontinence
For overflow incontinence:
- Provide pathophys and etiology
- Overflow incontinence (Chronic urinary retention)
- Pathophysiology: outlet obstruction OR bladder underactivity → loss of urine
- Etiology: post-surgery, aging, medication (antidepressants), neurological disorders, bad bladder habits
For functional/transient incontinence:
- Provide description, epidemilogy, and etiology (be specific with etiology)
- Functional/transient incontinence
- Description: patient unaware that he/she needs to urinate → leakage
- Epidemiology: elderly
- Etiology: UTI, restricted mobility, constipation, medications, psych/cognitive deficiency
- Drugs include: diuretics, antipsychotics, alpha-blocking agents
What are some other cuases of urinary incontinence?
- Other causes of urinary incontinence: urethral diverticulum, genitourinary fistula (pregnancy or past surgery), congenital abnormalities (bladder extrophy, ectopic ureter), detrusor hyperreflexia
How do you diagnose urinary incontinence? Be specific about indications, technique, and what the results of this diagnostic test mean.
- Diagnosis: Postvoid Residual Volume (PVR), urinalysis
- PVR
- Indications: symptoms of incomplete emptying, diabetes mellitus, past hx of urinary retention, failure of drug therapies, pelvic floor prolapse, past surgery
- Technique: ultrasound or catheterization
- Results: PVR < 50 – normal; PVR > 200 – not normal
- PVR
What are non drug or non-surg treatments for urinary incontinence?
- Treatment
- Fluid management – avoid caffeine/alcohol, or drinking lots of fluid at night
- Bladder retraining – regular voiding by clock
- Physiotherapy – pelvic floor exercises, vaginal cones (weights to build strength)
- Pessaries – devices that correct prolapse and hold up bladder
Provide drugs that can be used for urinary incontinence.
- Treatment
- Medications – oxybutynin (muscarinic (M3) antagonist → treats OAB), tolteridine (muscarinic (M3) antagonist → treats OAB), flavoxate (anticholinergic → relax smooth muscles), imipramine (beta agonist → treats OAB)
Provide surgical options for urinary incontience. What is the gold standard?
- Treatment
- Surgery: Burch repair, Marshall-marchetti-krantz repair, Sling (gold standard), injections (botox @ bladder or ureter)
What are the 4 types of prolapse?
Prolapse
- Types:
- Cystocele – protrusion of the bladder
- Rectocele – protrusions of the rectum
- Apical prolapse – uterine OR vaginal vault prolapse
- Procidentia – total prolapse of bladder AND uterus (rectocele may be present)
What is the epidemiology, pathophys, etiology, and treatment of prolapse?
- Epidemiology: common
- Pathophysiology: damage to pelvic floor structures → loss of support → prolapse
- Etiology: childbirth, aging, chronic stress/strain, congenital abnormalities
- Treatment:
- None – can be asymptomatic
- If symptomatic (not emptying properly)
- Pessary - devices that correct prolapse and hold up bladder
- Surgery
What is the grading scale of prolapse?
- Grading
- Grade I: Into the vagina but not to the introitus
- Grade II: To the introitus (vaginal opening) with strain
- Grade III: Through the introitus with strain
- Grade IV: Through the introitus at rest
For Normal, provide:
- Description of stroma and terminal duct lobular unit
- Consists of stroma: connective and fatty tissues, nerve and vessels
- Terminal duct lobular unit – most active part of breast tissue
What is this an image of?

Normal breast: Ducts lined by double layer of epithelial cells and surrounded by layer of myoepithelial cells
What is this an image of?

Normal breast
For fibrocystic change breast disease:
- Provide a description
- Age of onset?
- Most common benign breast disorder
- 20-40 y/o woman
- Hormone medicated
What is this?

Fibrocystic change: Bilateral, lumpy-bumpy, Blue domed cysts
What is this?

Fibrocystic change breast disease: Dilation of duct lobules, stromal fibrosis
What is this?

Fibrocystic changes breast disease: apocrine metaplasia
What is this?

Fibrocystic change breast disease: ductal ectasia
Describe breast abscess:
- Description:
- Complication
- Gross appearance
- Painful lump of inflammatory/purulent tissue
- Complication: fistula formation
- Gross: Unilateral, fibrous cavity with pus
What is this?

Breast abscess: Fibrous capsule with inflammatory infiltrates